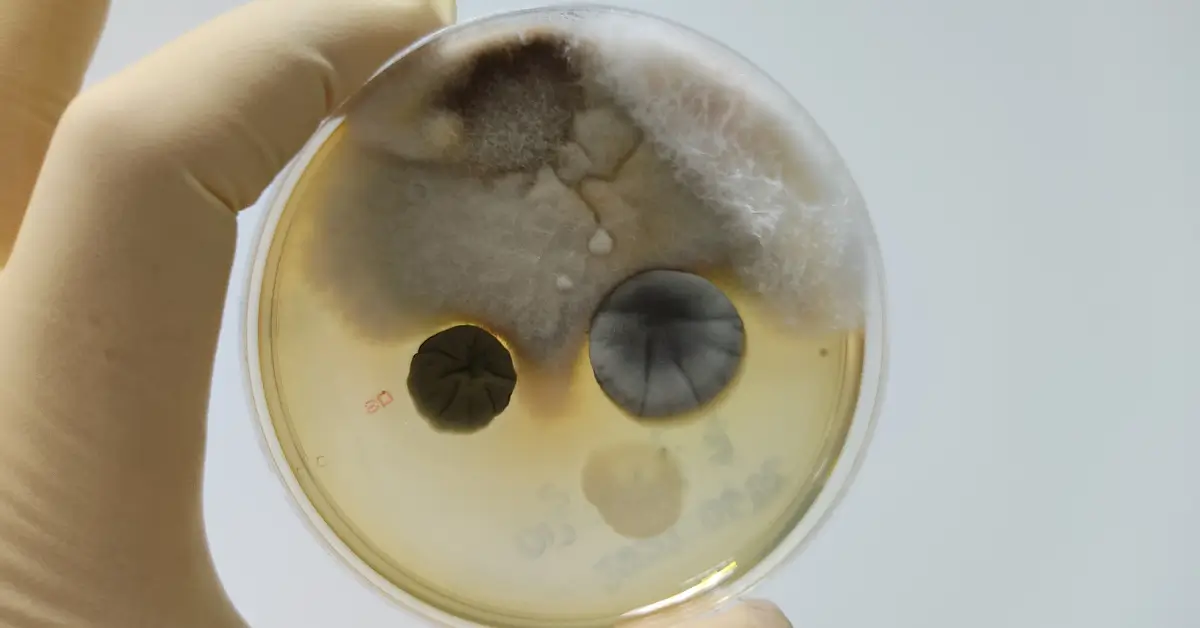

150+ Reviews
190+ Reviews
Rated by BBB








We’ve helped 5,000+ San Diego residents recover from water damage, mold issues, and fire loss. Here’s what your neighbors are saying:
Excellent rating
Based on 179 reviewsTrustindex verifies that the original source of the review is Google. Amazing customer service. Demo and dryout process went smoothly. Jimmy, Tony & Julian did a fantastic job. There attention to detail was spot on. I will highly recommend American Response Team to friends and family if they're in need of water damage services. Job we'll done boys!!!Trustindex verifies that the original source of the review is Google. Christian, Moises and the rest of the crew are outstanding! Honest, efficient, and kind. They are excellent communicators and very trustworthy. They do great quality work and are quick to respond. Definitely highly recommended!Trustindex verifies that the original source of the review is Google. We’ve had to call on American Response Team twice now—both times for the same general area in our home. The first time was about 2.5 years ago, and unfortunately, a new leak developed in the same area recently, this time coming from the toilet. Understandably, I was initially concerned that this might have been due to the original installation—perhaps a reused wax ring or something missed. However, I really appreciated how the owner, Will, handled the situation. He took the time to personally speak with me, look up our original file, and even went as far as sending photos from the original job showing that the wax ring installed was indeed brand new. That level of follow-through and transparency was very reassuring. Both times we’ve used them, their response time and communication have been excellent. They were professional, efficient, and respectful of our home. While I obviously hope I won’t need their services again anytime soon, it’s a relief to know that if I do, I’ll be in good hands. Highly recommend American Response Team for their integrity and customer service.Trustindex verifies that the original source of the review is Google. American Response Team is fantastic! Their crew is fast, efficient, and gets the job done right the first time. I’ve been consistently impressed by their professionalism and attention to detail. I highly recommend them to anyone looking for a reliable team to take care of their property—you’re in great hands!Trustindex verifies that the original source of the review is Google. Honest and professional.Trustindex verifies that the original source of the review is Google. This review covers the two water leaks at my condo during the past 4+ months. The water heater was replaced since I thought that it was leaking. About a week afterwards, I noticed that the carpet was very damp again. My plumber also noticed that the drywall adjacent to the water heater was very damp. He suggested that I call America Response to remediate the water damage caused by a leak from the upstairs condo. Christian from American Response set up fans with a dehumidifier for a four day dry out period. The reconstruction team from American Response removed the damaged drywall and observed the source of the leak from the upstairs water heater. The upstairs owner then presumably had the leaky pipe repaired. The reconstruction team did a fantastic job with the repairs (new drywall with insulation, retexturing with painting, and reassembly of affected cabinets and backsplash). American Response deserves a 5 stars rating in terms of communications and excellent work quality. Unfortunately, the repair didn't hold, so I had to call American Response to deal with a repeat water damage control recently. They again responded quickly and dried out the walls and carpeting to prevent any growth of mold/pathogens. I highly recommend American Response to deal with any water damage scenarios quickly and professionally so that you can have "peace of mind." Thank you, American Response Team.Trustindex verifies that the original source of the review is Google. Jimmy and Tony came out for 2 separate issues. Both were on time, very knowledgeable, thorough in their inspection, and very honest about their findings. They gave advice about how we could resolve the minor issues ourselves and didn’t require hiring them. This company is truly looking to help people and not just be hired for the money. If you’re looking for a knowledgable company with their honest opinion, call these guys! I’m so glad I did!Trustindex verifies that the original source of the review is Google. American Response Team did a nice job with remediation and reconstruction of our kitchen when we had a flood. I especially appreciate Arturo Meza who answered his phone when I called, got back to me when he said he would, and did what he said he would do. That's hard to find anymore.Trustindex verifies that the original source of the review is Google. Very professional, courteous, and great to work with.
Excellent rating
Based on 198 reviews
This review covers the two water leaks at my condo during the past 4+ months. The water heater was replaced since I thought that it was leaking. About a week afterwards, I noticed that the carpet was very damp again. My plumber also noticed that the drywall adjacent to the water heater was very damp. He suggested that I call America Response to remediate the water damage caused by a leak from the upstairs condo. Christian from American Response set up fans with a dehumidifier for a four day dry out period. The reconstruction team from American Response removed the damaged drywall and observed the source of the leak from the upstairs water heater. The upstairs owner then presumably had the leaky pipe repaired. The reconstruction team did a fantastic job with the repairs (new drywall with insulation, retexturing with painting, and reassembly of affected cabinets and backsplash). American Response deserves a 5 stars rating in terms of communications and excellent work quality. Unfortunately, the repair didn’t hold, so I had to call American Response to deal with a repeat water damage control recently. They again responded quickly and dried out the walls and carpeting to prevent any growth of mold/pathogens. I highly recommend American Response to deal with any water damage scenarios quickly and professionally so that you can have “peace of mind.” Thank you, American Response Team.
Jimmy and Tony came out for 2 separate issues. Both were on time, very knowledgeable, thorough in their inspection, and very honest about their findings. They gave advice about how we could resolve the minor issues ourselves and didn’t require hiring them. This company is truly looking to help people and not just be hired for the money. If you’re looking for a knowledgable company with their honest opinion, call these guys! I’m so glad I did!
July 2024, pipe burst causing water damage to kitchen and 2 bathrooms. American Response Team handled the cleanup and repairs. 9 months later, work is complete. I would like to thank Moises Cibrian, Operations Manager, for coordinating the repairs. Thank you for your help and patience. In particular, however, I commend Arturo Meza, Project Coordinator. When things got dicey due to insurance issues, communication issues, work quality, etc., I could always count on Arturo to answer my calls for help in a matter of minutes. He was always able to resolve issues in a timely manner and keep me informed. Dependable, available, reliable, a true professional. And he kept me sane, seeing me through the entire process. Additionally, I want to thank all of the mitigation folks and vendors for their hard work.
Since its inception, American Response Team has set the standard for water damage restoration in San Diego. Our proven methods and highly trained technicians ensure that every water damage cleanup exceeds industry expectations—from the first call to the final walkthrough.
Whether it’s a burst pipe, a monsoon flood, or an appliance leak, flooding is one of the most common and destructive emergencies homeowners face. The sooner you act, the better your outcome. That’s why the first thing you should do is call our 24/7 team to mitigate, prevent, and repair the damage before mold sets in or structural materials deteriorate.
Using state-of-the-art restoration technology—including moisture mapping, thermal imaging, HEPA air filtration, and EPA-registered antimicrobials—we respond fast and thoroughly. Our certified experts extract standing water, dry affected areas, and assess moisture levels to prevent long-term problems like rot and mold.
And we don’t just handle water.
We’re also San Diego’s trusted pros for:
Seven days a week, 365 days a year—daytime or nighttime—our team is ready to help you take control. We restore more than property—we restore peace of mind.
Serving homeowners across La Jolla, Mission Valley, Chula Vista, Oceanside, and every corner of San Diego County.
One call gets help moving—fast.

We offer a full suite of restoration services across San Diego County—all performed by our in-house team of licensed, bonded, and IICRC-certified professionals.
Safe and discreet removal of hazardous materials, blood, and contaminants with full sanitization—restoring your space to a safe condition.
From soot removal and odor control to structural repairs, we restore homes and businesses after fire so you can rebuild safely.
Rapid water extraction, drying, and sanitization after floods—protecting against structural damage and mold growth.
Emergency water extraction, drying, and repair to stop further damage and prevent mold infestations.
Fast removal, disinfection, and deodorization of sewage backups—eliminating dangerous bacteria and restoring safety.
Complete reconstruction services after water, fire, or mold damage—bringing your property back to pre-loss condition.
Safe removal of mold using EPA-approved methods, HEPA filtration, and antimicrobial treatments for long-term protection.
Thorough inspections, moisture mapping, and air testing to detect hidden mold and prevent health risks early.
Advanced technology to pinpoint hidden leaks in walls, slabs, and plumbing systems before they cause costly damage.

When disaster strikes your home or business, you need more than just a cleanup crew. You need a team who knows the stakes, the standards, and how to get your life back to normal fast.
Our rapid response team is on call around the clock. Whether it’s 2 AM on a Sunday or Thanksgiving Day, we answer—and we act.
Every technician on your job is IICRC-certified. We stay current with the latest restoration techniques, health standards, and San Diego-specific challenges.
You won’t need to manage multiple vendors or juggle communications. We handle the entire process—from assessment and mitigation to final paint touch-ups.
We speak insurance fluently. We document all damage, use Xactimate billing, and work directly with your adjuster to advocate for maximum coverage—with minimal stress.
Your safety is our priority. We use only EPA-approved products, advanced HEPA filtration systems, and containment strategies to protect your home and health—especially from hidden mold or biohazards.
We work with many top insurance carriers and restoration networks. Our team knows the ins and outs of coverage, deductibles, documentation, and how to negotiate with your provider.










Need help understanding your policy? We’ll walk you through it.
If you’re worried about mold in your home, you might be confused about mold inspection vs mold testing. These

Discovering that your neighbor flooded your property can be shocking and overwhelming. You’re looking at water damage, soggy yards,

Getting your water damage claim denied is frustrating and scary. You’re already dealing with wet floors, damaged walls, and